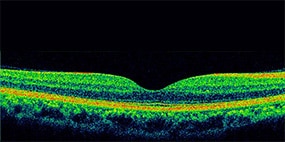
正常

糖尿病網膜症とは
糖尿病網膜症、糖尿病黄斑浮腫とは
糖尿病網膜症は、糖尿病で血糖値が高い状態が続くことにより起こる合併症で、三大合併症と呼ばれる代表的な合併症のひとつです。
長い期間、血糖値の高い状態が続くと、網膜にはりめぐらされている細かい血管(毛細血管)が傷ついたり、つまったりして起きる病気です。病気の初期では、見え方に変化はありませんが、放っておいて病気が進行すると、ゆがみや見えないところが現れます。
糖尿病黄斑浮腫は、糖尿病網膜症のいずれの病期においても合併することがあります。糖尿病黄斑浮腫は、網膜の細い血管にコブができたり、血管から血液中の成分がもれだし、それが網膜内にたまっている状態です。そのため、ものの詳細を見分けたり、文章を読んだりするのにとても大切な場所、「黄斑」がむくんでしまい、ものが見えづらくなります。

正常な状態

糖尿病網膜症、糖尿病黄斑浮腫
日本における糖尿病網膜症
糖尿病網膜症の有病率は15.0~23.0%との報告があります。患者数は大きく増加していませんが、糖尿病患者数が増加しており、今後、糖尿病網膜症も増加する可能性が指摘されています。
■ 糖尿病網膜症の有病率

久山町研究:40歳以上の住民を対象に実施
舟形町研究:35歳以上の住民を対象に実施
安田美穂:あたらしい眼科 28(1):25-29,2011
川崎良:日本の眼科 79(12):1697-1701,2008
糖尿病網膜症になりやすい人
糖尿病網膜症の発症リスクを高めるのは、糖尿病歴とHbA1cとの報告があります。糖尿病歴は10年以上、HbA1cは7.0%以上だと、糖尿病網膜症の発症リスクが高くなります。
血糖値を良好に保つことは、糖尿病網膜症だけでなく、ほかの糖尿病合併症も遠ざけることに繋がりますので、よりよい血糖コントロールをめざしましょう。
| HbA1c(JDS値)(%) | 人数 | 9年発症率(%) |
|---|---|---|
| <6.0 | 59 | 5.1 |
| 6.0~7.0 | 34 | 11.8 |
| 7.0~8.0 | 12 | 25.0 |
| 8.0≦ | 11 | 45.5 |
| 糖尿病罹病期間(年) | 人数 | 9年発症率(%) |
|---|---|---|
| <5 | 71 | 8.5 |
| 5~10 | 14 | 14.3 |
| 10≦ | 31 | 22.6 |
久山町研究:40歳以上の住民を対象に実施
安田美穂:あたらしい眼科 28(1):25-29,2011
糖尿病網膜症の進行
糖尿病網膜症は、単純網膜症→増殖前網膜症→増殖網膜症と進行します。
黄斑浮腫はいずれの病期においても合併することがあります。
①正常

②単純網膜症
毛細血管がやぶれ始め、血管にコブができたり(毛細血管瘤(りゅう))、出血したりします(点状出血)。また、やぶれた血管から、血液や血液中の成分がもれだします。
黄斑浮腫が合併することがあります。

毛細血管瘤/点状網膜出血
③増殖前網膜症
血管の障害が繰り返されることで血管壁が厚くなり、血管が狭くなったり、つまったりして(血管閉塞)、血液が網膜に十分に流れなくなる(虚血)状態です。
黄斑浮腫が合併することがあります。

血管閉塞/虚血
④増殖網膜症
虚血になると、網膜では、新しい血管が作られます(新生血管)。新生血管はもろく、壊れやすいので、出血を起こすことがあります。また、硝子体(しょうしたい)に膜ができ、その膜が収縮して硝子体と網膜を癒着(ゆちゃく)させ、網膜を引っ張り、網膜剝離(はくり)を引き起こすこともあります(牽引(けんいん)性網膜剥離)。
黄斑浮腫が合併することがあります。

新生血管/出血/牽引性網膜剥離
専門医のための眼科診療クオリファイ:16 糖尿病眼合併症の新展開.白神 史雄編.1 網膜症
池田誠宏 著 中山書店,17-23,2013より改変
ものが見える仕組み
目に入った光は、角膜・水晶体などで屈折し、網膜に達した後、脳で認識されます。カメラにたとえると、角膜・水晶体はレンズ、網膜はフィルムのはたらきをしています。

<人の仕組み>

<カメラの仕組み>
視力の大切な役割を担う「黄斑」
網膜は、はりめぐらされた血管により栄養を補給され、そのはたらきが保たれています。
網膜を正面から見ると、ほぼまん中に黄斑と呼ばれる、ほかの部分より少し黄色く見える部分があります。黄斑はものの詳細を見分けたり、文字を読んだりするのにとても大切な場所です。

<正常な黄斑部>

黄斑はものの詳細を見分けたり、文字を読んだりするのにとても大切な場所なんだ
見え方の変化
黄斑浮腫が起こると、網膜がむくみ、出血が起きることもあります。そのため、かすんで見えたり、見えないところができたり、ゆがみが生じたりします。
<かすんで見える>

<ゆがんで見える>

<見えない部分がある>


網膜に出血やむくみがあるから、
かすんで見えたり、見えない部分やゆがみが生じるんだね
眼科の検査
糖尿病網膜症や糖尿病黄斑浮腫を診断するため、もしくは治療の経過をみるために、主に次のような検査が行われます。
・視力検査
指定の距離から、視力検査表を片眼ずつ見て、どの大きさまで見えるか調べます。
見えにくい場合は、検査表に近づいて測定します。

・眼底検査
目の奥に光りをあてて、網膜を直接観察します。
網膜の血管の様子、出血や網膜のむくみ(黄斑浮腫)の状態を見ることができます。
<正常>

<糖尿病網膜症、糖尿病黄斑浮腫>

・蛍光眼底造影
蛍光色素の入った造影剤を腕の静脈から注射して、眼底カメラで眼底の血管を観察します。
血管の形や位置、血管からの血液中の水分のもれ具合などがわかります。
<正常>

<糖尿病網膜症、糖尿病黄斑浮腫>

※検査の際には造影剤を注射するため、まれに吐き気や嘔吐、アレルギー反応などの副作用が起きることがあります。
検査中に何か異常を感じたら、速やかに医師に伝えてください。
・光干渉断層計(OCT)
網膜は層構造になっており、その層構造を断面的に観察する検査です。
網膜のむくみ(黄斑浮腫)の状態がわかります。
<正常>
<糖尿病網膜症、糖尿病黄斑浮腫>

・その他の検査
心電図のように網膜の電位変化を記録して、その波形から網膜のはたらきを調べる「網膜電図」を行うこともあります。

自分の症状を知るためにも、まず検査!
気になったらすぐ病院へ!
糖尿病黄斑浮腫の治療法
糖尿病黄斑浮腫に対して、現在行われている主な治療法には以下のものがあります。
抗VEGF薬治療
糖尿病網膜症に伴う糖尿病黄斑浮腫には、VEGFという物質が関与しています。そのため、VEGFのはたらきを抑えるお薬を目に注射します。
ステロイド薬治療
ステロイド薬には炎症を抑える作用があります。そのため、ステロイド薬を目に注射して、黄斑のむくみを抑えるようにします。
レーザー光凝固
① 直接光凝固
血管にできたコブや血液成分がもれだしている血管にレーザー光線をあて、焼き固めます。
② 格子状凝固
むくみのあるところに、格子状にレーザー光線をあて、むくみを改善します。
硝子体手術
網膜剥離や硝子体出血が起こっている場合に行われる手術です。眼の中の出血を止め、異常な組織を取り除いたり、はがれた網膜を元に戻したりします。

糖尿病黄斑浮腫に対しては
様々な治療法があるんだね
血糖管理目標※
よりよい血糖コントロールは、糖尿病の治療だけではなく、合併症を遠ざけるためにも大切です。
HbA1cは7.0%未満をめざしましょう。
長期にわたって血糖コントロール不良であった場合には、急激な血糖値の低下により、網膜症が悪化する場合があるので、眼科医と相談しながら、よりよい血糖コントロールをめざしましょう。
※65歳以上の高齢者については「高齢者糖尿病の血糖コントロール目標」(「高齢者糖尿病診療ガイドライン」日本老年医学会、日本糖尿病学会編・著)を参照
■ 血糖コントロール目標

治療目標は年齢、罹病期間、臓器障害、低血糖の危険性、サポート体制などを考慮して個別に設定する。
注1)適切な食事療法や運動療法だけで達成可能な場合、または薬物療法中でも低血糖などの副作用なく達成可能な場合の目標とする。
注2)合併症予防の観点からHbA1cの目標値を7%未満とする、対応する血糖値としては、空腹時血糖値130mg/dL未満、食後2時間血糖値180mg/dL未満をおおよその目安とする。
注3)低血糖などの副作用、その他の理由で治療の強化が難しい場合の目標とする。
注4)いずれも成人に対しての目標値であり、また妊娠例は除くものとする。
日本糖尿病学会編・著:糖尿病治療ガイド2022-2023,P34,文光堂,2022
血圧管理目標
血圧のコントロールも糖尿病合併症の発症・進行に有用です。
収縮期血圧130mmHg未満、拡張期血圧80mmHg未満をめざしましょう。
糖尿病網膜症の病期に応じた推奨眼科検診頻度
糖尿病網膜症の初期は、自覚症状がほとんどないことも少なくありません。早期発見は早期治療に繋がります。主治医の指示に従って、定期的な眼科の診察を受けましょう。
■受診間隔の目安
網膜症なし・・・1回/1年
単純網膜症・・・1回/6か月
増殖前網膜症・・・1回/2か月
増殖網膜症・・・1回/1カ月
日本糖尿病学会編・著:糖尿病治療ガイド2022-2023,P85,文光堂,2022

糖尿病眼手帳
日本糖尿病眼学会から、無料で「糖尿病眼手帳」が発行されています。
糖尿病網膜症についての解説のほか、眼科や内科の診療内容や検査結果を記入することもできます。


監修 名古屋大学未来社会創造機構 特任教授 寺﨑 浩子 先生



